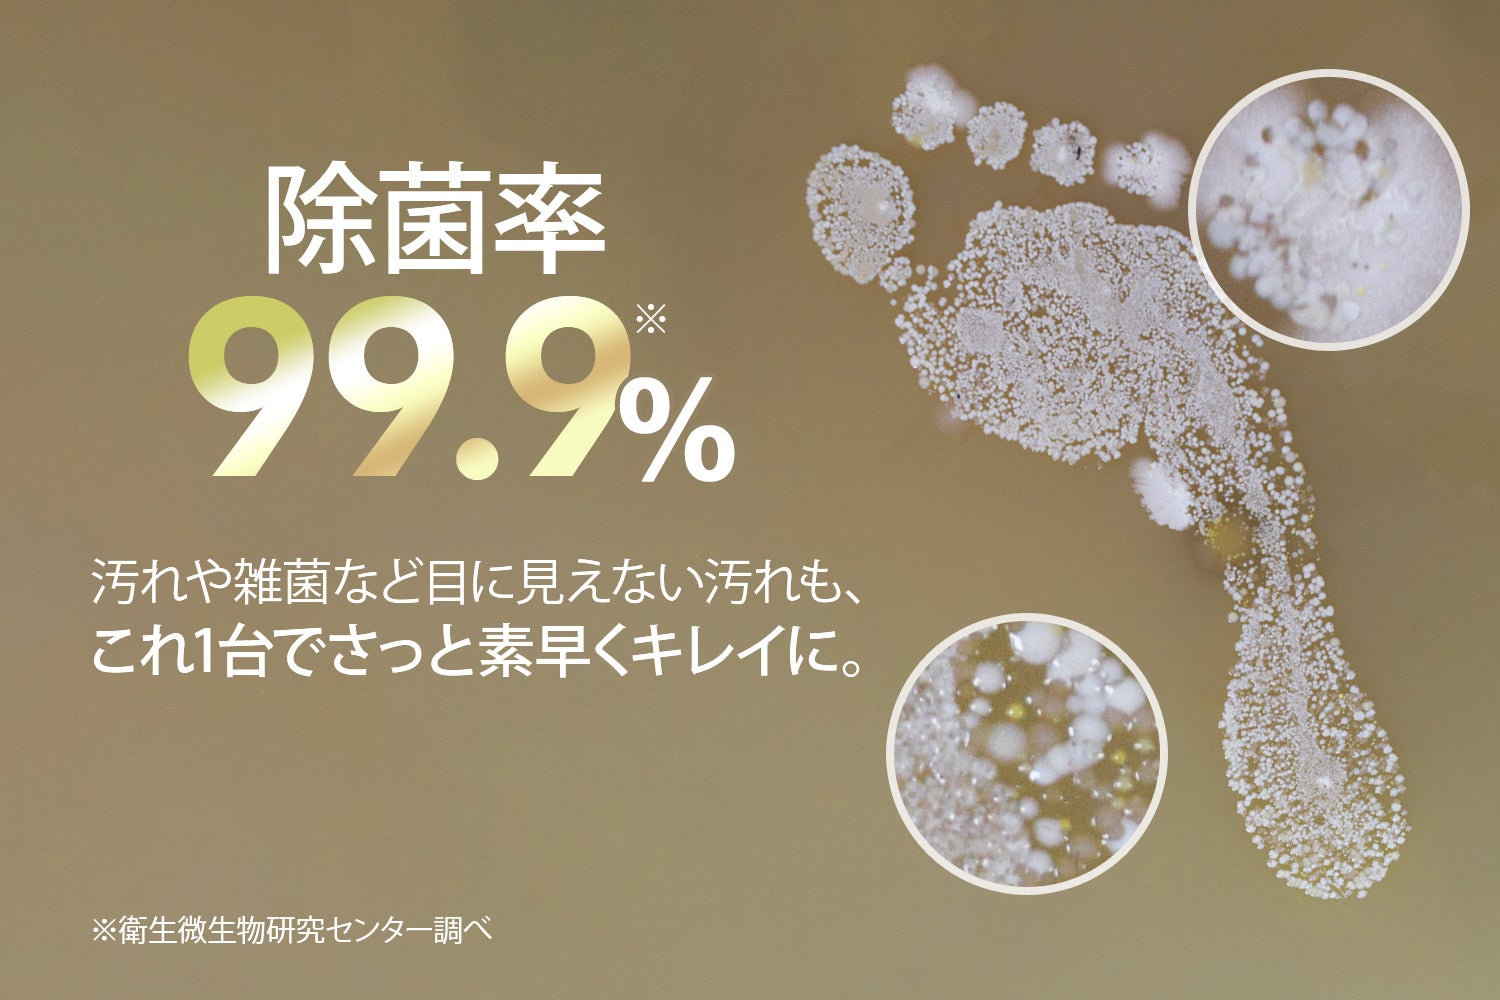

話題のストレスフリー掃除機『MINDOO AquaX』が日本初上陸!お得なキャンペーン付で予約販売を開始
2つの特許技術を用いた吸引・⽔拭き・セルフクリーニングの3in1機能で、これまでの掃除時間を75%削減。予約販売期間中(〜8⽉31⽇)は90⽇間フリーレンタル&ロールブラシ1本を無料プレゼント
株式会社Mindoo Technology(本社:東京都港区、代表取締役:金京美、読み:ミンドーテクノロジー、以下「当社」)は、吸引&水拭きが同時にできるストレスフリー掃除機『MINDOO AquaX』を、7月20日(木)より公式サイト(https://mindoo.co.jp/)にて予約販売開始いたします。

■発売の背景
withコロナ時代を経て、外出自粛の生活が続き、自宅で過ごす時間を快適にしたいと感じている人が増加傾向にあります。コロナ渦で在宅時間が増え、多くの方が家事の大変さ、とくに床掃除が既存の掃除方法では満足にできないという現状に不満を抱いていることに着目し、第一弾である 『MINDOO AquaX』の開発に至りました。

日本でのオーソドックスな掃除方法は、掃除機をかけた後にフロアワイパーや雑巾がけをするというのがほとんどです。また、フロアワイパーの使用には継続的に専用シートを購入する必要があり、なにより時間もお金もかかります。
例えばコストパフォーマンスでいうと、コードレス掃除機(70,000円)+フロアワイパー1年間分(10,000円)で合計80,000円かかるものが、『MINDOO AquaX』だと54,800円で完結いたします。
タイムパフォーマンスに関しても、掃除機掛け15分+水拭き掃除30分、合計45分かかるものが、『MINDOO AquaX』があれば掃除機掛けと水拭き掃除が15分でお掃除が完了いたします。

AquaXは1台で吸引・水拭き・セルフクリーニングの機能が搭載された3in1のストレスフリー掃除機です。
「キッチン周りのベタベタが気になる」、「洗面所が髪の毛と埃、液体汚れでびしょびしょ」、「小さい子供、ペットがいるので花粉や泥、除菌をしっかりしたい」、「雑巾がけをしたいが、膝や足腰が痛くてなかなかできない」という家事のストレスを解消サポートいたします。
◼️これ1台で、生活が変わる。「MINDOO AquaX」 7月20日(木)より販売開始
予約販売期間限定、フリートライアル90日間&ロールブラシ(4,950円)1本無料キャンペーンを実施

「購入したけど結局使わなくて、タンスの肥やしになっている…」こういった経験はありませんか?
Mindooは皆様の生活に寄り添える製品を提供・開発していきたいと考えています。
そのため、新しい掃除体験を皆様に楽しんでいただきたいという私たちの想いから、予約販売期間中(7月20日~8月31日)にご購入いただいたお客様には、90日間のフリートライアル期間を設けています。
■1台で「吸引・水拭き・セルフクリーニング」ができる次世代のストレスフリー掃除機

吸引、水拭き、セルフクリーニングの3in1機能を備えた『AquaX』は、これまでの掃除ストレスを大幅に軽減。
一度の作業で三つの掃除工程を一気にこなすことで、掃除時間の75%を削減いたします。
材質テストを10回以上重ねたどり着いた高密度ポリエステル化学繊維ロールブラシや、
1分間に540回転というロールブラシの摩擦力で、力を入れないとなかなか落とせない油や皮脂汚れにアプローチいたします。
■除菌率99.9%※1で安全に、皆様の生活をまもります。
子育てはピンチの連続。
子どもが勢いよく食べ物や飲み物をこぼしてしまっても。ゆっくり掃除している時間はありません。
さらに、掃除したばかりなのに気がついたら「べたべた」「ざらざら」になっているフローリング…。
汚れや雑菌など目に見えない汚れも、これ1台でさっと素早くキレイに。
※1 衛生微生物研究センター調べ
■日本の家庭に適した体感0.9kg※2の軽量・小型設計

本体部分にまとめて浄水タンクと汚水タンクが設置されているのが一般的な水拭き掃除機。
一方で、『MINDOO AquaX』は浄水タンクをヘッド部分に設置いたしました。
これにより、小さな本体サイズと低い重心に。
女性やお子様でも〃らくらく〃操作ができるようになりました。
※2 引張力計を用いて計測 自社工場調べ
■お部屋の汚れに合わせて選べる3つのモード

ウェットモード レベル1
水パワーで塵や軽めの汚れを除去。デイリー使いにおすすめです。

ウェットモード レベル2
レベル1では落としきれなかったしつこい油汚れや皮脂汚れを除去。
カピカピになった飲みこぼしや、ペットの肉球のあとにもおすすめです。

ドライモード
濡らしたくない、畳やカーペットに、普通の掃除機として。
【主な商品特徴】
①一台で吸引・水拭き・セルフクリーニングの3in1
② 除菌率99.9%※1で安全に、皆様の生活をまもります。
③日本の家庭に適した体感0.9kg※2の軽量・小型設計
④自走式ヘッドで力がいらず、らくらくお掃除
⑤お部屋の汚れに合わせて選べる3つのモード
⑥3時間の充電で最長35分間の掃除が可能
⑦90日間のフリートライアルで、返金・返品保証
※1 衛生微生物研究センター調べ
※2 引張力計を用いて計測 自社工場調べ

【商品概要】
製品名:「MINDOO AquaX」
発売日:2023年7月20日(木)
価格:54,800円(税込)
※予約販売期間中限定フリートライアル90日間
カラー展開:クリームベージュ/チャコールブラック
<MINDOOについて>

「MINDOO」というブランド名は、「infinity∞無限」という概念から生まれています。
中国古代道教の先駆者である荘子は、「吾生也有涯、而知也无涯」という言葉を残しました。
これは「命には限りがあるが、知識への追求は無限である」という意味です。
そして私たちMINDOOも、その哲学に深く共感しています。
思考に限界はない、というMINDOOのブランド名は、この言葉にインスピレーションを受けています。
その名前に恥じぬよう、私たちは有限な人生の中で無限の可能性を追求し続け、期待を超える感動的な体験をお届けしてまいります。
【発売日】2023年7月20日(木)
【会社概要】
■ 社 名:株式会社Mindoo technology(ミンドーテクノロジー)
■ 本社所在地:東京都港区三田 1-3-39 勝田ビル 6F
■ 設 立:2022年12月
■ 事業内容:掃除用品の企画・製造・販売
■ コーポレートサイト:https://mindoo.co.jp/
【お客様からのお問合せ先】
株式会社Mindoo technology
TEL:03-6722-0547
営業時間:平日10:00~17:00 定休日:土・日・祝日
【公式SNS】
・Instagram:https://www.instagram.com/mindoo_jp/
・Facebook:https://www.facebook.com/profile.php?id=100092509003355
・Youtube:https://www.youtube.com/channel/UCrRB-PWYypQ9L5OBT2daI7Q
このプレスリリースには、メディア関係者向けの情報があります
メディアユーザー登録を行うと、企業担当者の連絡先や、イベント・記者会見の情報など様々な特記情報を閲覧できます。※内容はプレスリリースにより異なります。
すべての画像
